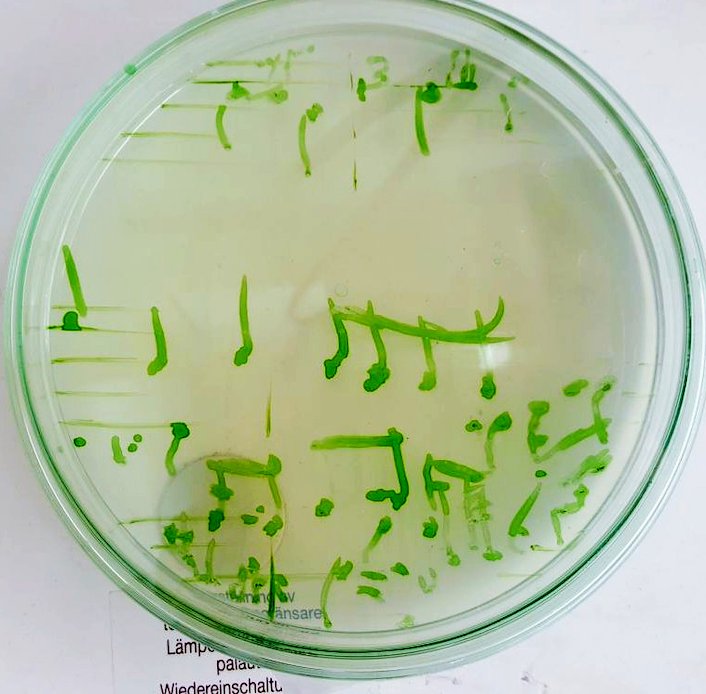

week 6/ 2018
Drawing and painting Bach`s handwritten mathematical harmonies at Biochemisrty Department in Turku University.

week 6/ 2018
Drawing and painting Bach`s handwritten mathematical harmonies at Biochemisrty Department in Turku University.